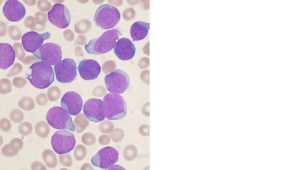

September is Childhood Cancer Awareness Month. This important event was announced in 2012 and made official in 2019 by the US Congress.
The goals of Childhood Cancer Awareness Month include honoring children and families affected by cancer, raising awareness of the importance of childhood cancer research, and recognizing the importance of cancer prevention and treatment.
When it comes to childhood cancer, there is good news and bad news. The bad news is that the rates of many childhood cancers have risen in recent decades. The good news is that survival has been increasing for many cancers and for childhood cancer overall, and research is leading to advances in treatment for some childhood cancers.
Childhood Cancer Facts and Changing Rates
In the US, cancer is the second leading cause of death for children between the ages of 1 and 14, after accidents. Leukemias, lymphomas, and brain and nervous system cancers are the most common types among those under age 19.
Over 15,000 children and adolescents are diagnosed with cancer each year in the US.
Acute lymphoblastic leukemia is among the most common pediatric cancers.
Rates of childhood cancer have trended upward since the 1970s. Between 1975 and 2016, overall childhood cancer rates rose 27%, with childhood leukemia rates rising by 35%. Similarly, a 2020 study found a 29.6% increase in cancers among adolescents and young adults between 1973 and 2015.
The causes of this increase are disputed. Environmental factors may be involved, especially for certain cancers. Some studies have linked childhood leukemias in particular to exposures including air pollution, solvents, pesticides, medical radiation (such as from X-rays and scans), and parental smoking. Better testing leading to more accurate diagnosis may also be a contributing factor.
Recent Research could improve Childhood Cancer Treatment
Over the past few decades, childhood cancer research has paid off. Improvements in treatment have driven down the mortality rate due to childhood cancer by more than 50% since 1975, and the survival benefits for some specific cancers are even more impressive.
Still, it is estimated that over 1,700 children and adolescents die from cancer each year in the US. Some types of cancer lag behind and still have low survival rates.
Rhabdomyosarcoma – a cancer of the muscles and soft tissues – currently has an estimated 66% five-year survival rate when diagnosed in those under age 19. Recent discoveries could help drug developers find new paths to treat this disease.
One study has uncovered mutations in several genes associated with the development of this cancer. Doctors may be able to use this information to help predict a patient’s prognosis and response to therapy based on which mutation(s) their tumor is carrying.
Other rhabdomyosarcoma research is highlighting a gene called AVIL. In 2020, AVIL was discovered to be involved in glioblastoma, a deadly type of cancer with few treatment options. The authors of a June 2022 study report that AVIL is activated in many pediatric rhabdomyosarcoma tumors. In both glioblastoma and rhabdomyosarcoma, the authors showed that silencing AVIL could kill tumor cells in a dish and prevent tumor growth in mice.

Rhabdomyosarcoma tumor cells. Recent discoveries could contribute to future drug development for this rare childhood cancer.
Changing Outlook for Pediatric Cancer Survivors
Most childhood cancer survivors will have long-term effects from their cancer treatment, and many will have permanent disabilities such as hearing loss and damage to the heart or other organs. Survivors also face an increased risk of second cancers developing down the line.
One recent study found that survivors of pediatric cancer had significantly higher risks of developing inpatient infections, even more than 5 years after their initial diagnosis. Other research shows that survivors face a greatly increased risk of heart failure and other cardiac diseases, especially if they were treated with radiation or certain chemotherapy drugs.
In light of these challenges and the growing number of pediatric cancer survivors, research into how to protect survivors’ health is critical. Many doctors are now recommending frequent and regular monitoring of cancer survivors’ heart health and other aspects of health. Exercise and other preventive measures could also be beneficial.

MDForLives is a vibrant community of healthcare professionals and patients dedicated to shaping the future of healthcare. We provide valuable global insights to healthcare companies through online surveys, interviews, and discussion forums.


